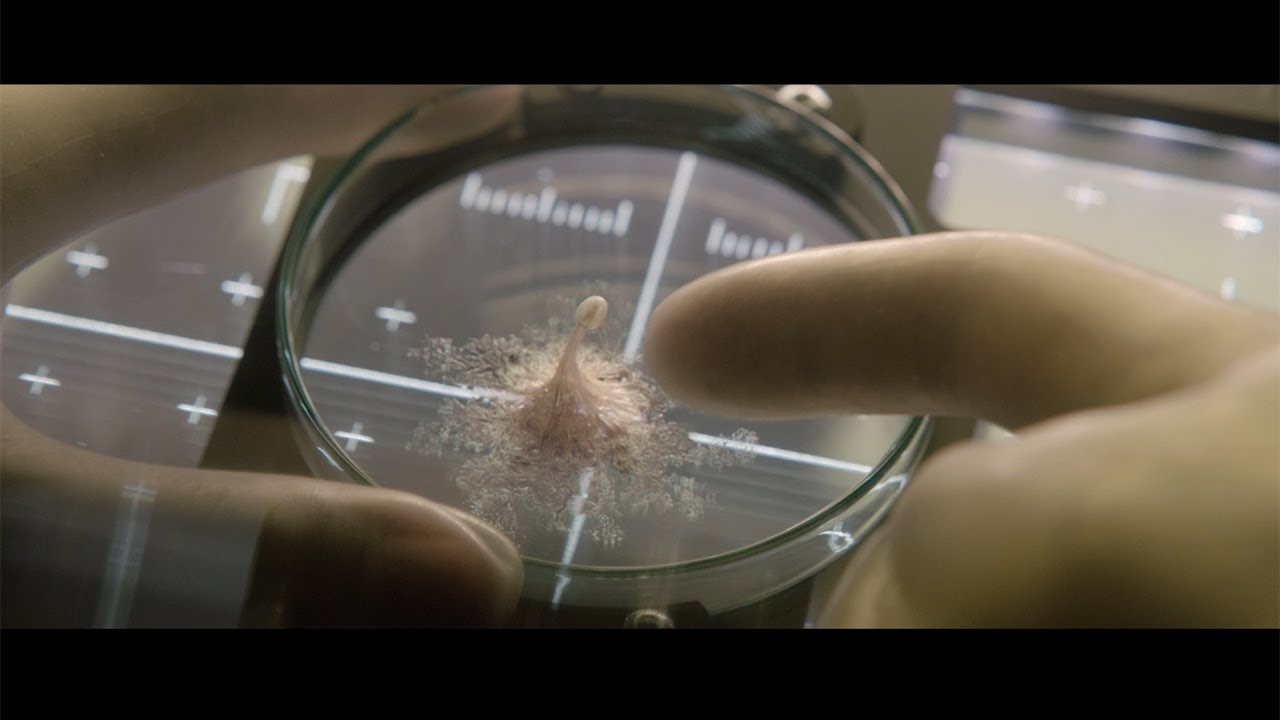

未知の生命体を発見した6人の宇宙飛行士に降りかかる恐怖を描いたSFホラー「ライフ」(ダニエル・エスピノーサ監督)が8日から丸の内ピカデリー(東京都千代田区)ほかで公開される。地球外生命体「カルビン」の造形が新鮮。クルー最年長のシステムエンジニアのムラカミ役、真田広之さんの存在感が光る。
あなたにオススメ

トムとジェリー:フル3DCGの新作劇場版「時をこえる魔法の羅針盤」が全世代に“刺さる”理由
国際宇宙ステーション(ISS)に乗り込んでいた6人の宇宙飛行士が、火星で採取した土壌を調べると、アメーバ状の微生物が見つかる。「カルビン」と名付けられ、宇宙生物学者デリー(アリヨン・バカレさん)の献身的な世話で細胞分裂を繰り返しながら急速に成長していく……というストーリー。ほかに米俳優ジェイク・ギレンホールさん、カナダ出身のライアン・レイノルズさん、スウェーデン出身のレベッカ・ファーガソンさんらが出演している。
初めて発見された地球外生命体が、アメーバ状の微生物というところが現実にもありそうで恐ろしい。知能が高く、好奇心も旺盛で、デリーの指先に絡みついたり、ツクシのような形で立ち上がったりと、結構カワイイやつだ。姿や仕草に一瞬ほだされるが、その思いは見事なまでに覆される。しかし、カルビンとて生きるのに必死なわけで、カルビンと乗組員の壮絶な死闘は、昨今の地球外生命体の発見に躍起になる人類への警告とも取れる。
ムラカミの活躍も特筆すべきだ。地球に残してきた身重の妻を気に掛けながら任務に当たる彼は、非常に冷静で頼れる男だ。米国、英国、カナダ、スウェーデン、ロシア出身と国際色豊かなキャストの中で存在感を示している。(りんたいこ/フリーライター)
映画 最新記事
-

トイ・ストーリー5:おもちゃと人間の絆 シリーズの集大成、感動のラストを予感させる日本版予告解禁
ディズニー&ピクサーのアニメーション映画「トイ・ストーリー」の最新作「トイ・ストーリー5」(アンドリュー・スタントン監督、ケナ・ハリス共同監督)が7月3日に日本で公開される(全米…
1 -

ブルーロック:実写映画 主題歌はAdo エゴ剥き出しの激闘描く本予告 高橋文哉が躍動!
「週刊少年マガジン」(講談社)で連載中の人気サッカーマンガが原作の実写映画「ブルーロック」(瀧悠輔監督、8月7日公開)で、歌手のAdoさんが主題歌「モンストロ」を担当することが明…
1 -

イベント 香取慎吾:10歳で見た東京ドームライブ 「目が合って、マイケルのようにステージで輝きたい」 マイケル愛を熱弁
香取慎吾さんが6月4日、東京都内で行われた映画「Michael/マイケル」(アントワーン・フークア監督、6月12日公開)ジャパンプレミアレッドカーペットパーティーに出席。マイケル…
1 -

イベント SixTONESジェシー:「めるるとぱるるを…」 劇場版「ケロロ軍曹」で一人二役 「“じぇしじぇし”広めて」
人気グループ「SixTONES」のジェシーさんが6月3日、東京都内で行われた、「新劇場版☆ケロロ軍曹 復活して速攻地球滅亡であります!」(福田雄一総監督、6月26日公開)の完成披…
1 -

永尾柚乃:愛されキャラ、グローグーがいっぱい? 会場を見渡し「可愛いですね~」
人気子役の永尾柚乃さんが俳優の伊藤英明さんと6月3日、東京都内で開催された映画「スター・ウォーズ/マンダロリアン・アンド・グローグー」(ジョン・ファブロー監督)の大ヒット記念舞台…
1 -
イベント 山崎賢人:「キングダム」信役を演じて8年「もう1個の自分の人生のよう」 最新作への思い語る「王騎将軍がいなくても…」
-
キャスト 松岡茉優:人気小説「男ともだち」映画化で主演 “男ともだち”に7年ぶり共演の成田凌
-
イベント 坂口憲二:「キングダム」人気キャラ・桓騎役にプレッシャーも「できることは全部やって臨もう」 スーツ姿でも「桓騎を表現」 会場からは拍手
-
映画興行成績:「スター・ウォーズ/マンダロリアン・アンド・グローグー」V2 新作は「箱の中の羊」「劇場版モノノ怪」「TOKYO BURST」
-
イベント 有村架純:シンガポールで全力疾走「こけました」 30歳を過ぎて急に走ると「危ない」と反省 主演映画「マジカル・シークレット・ツアー」